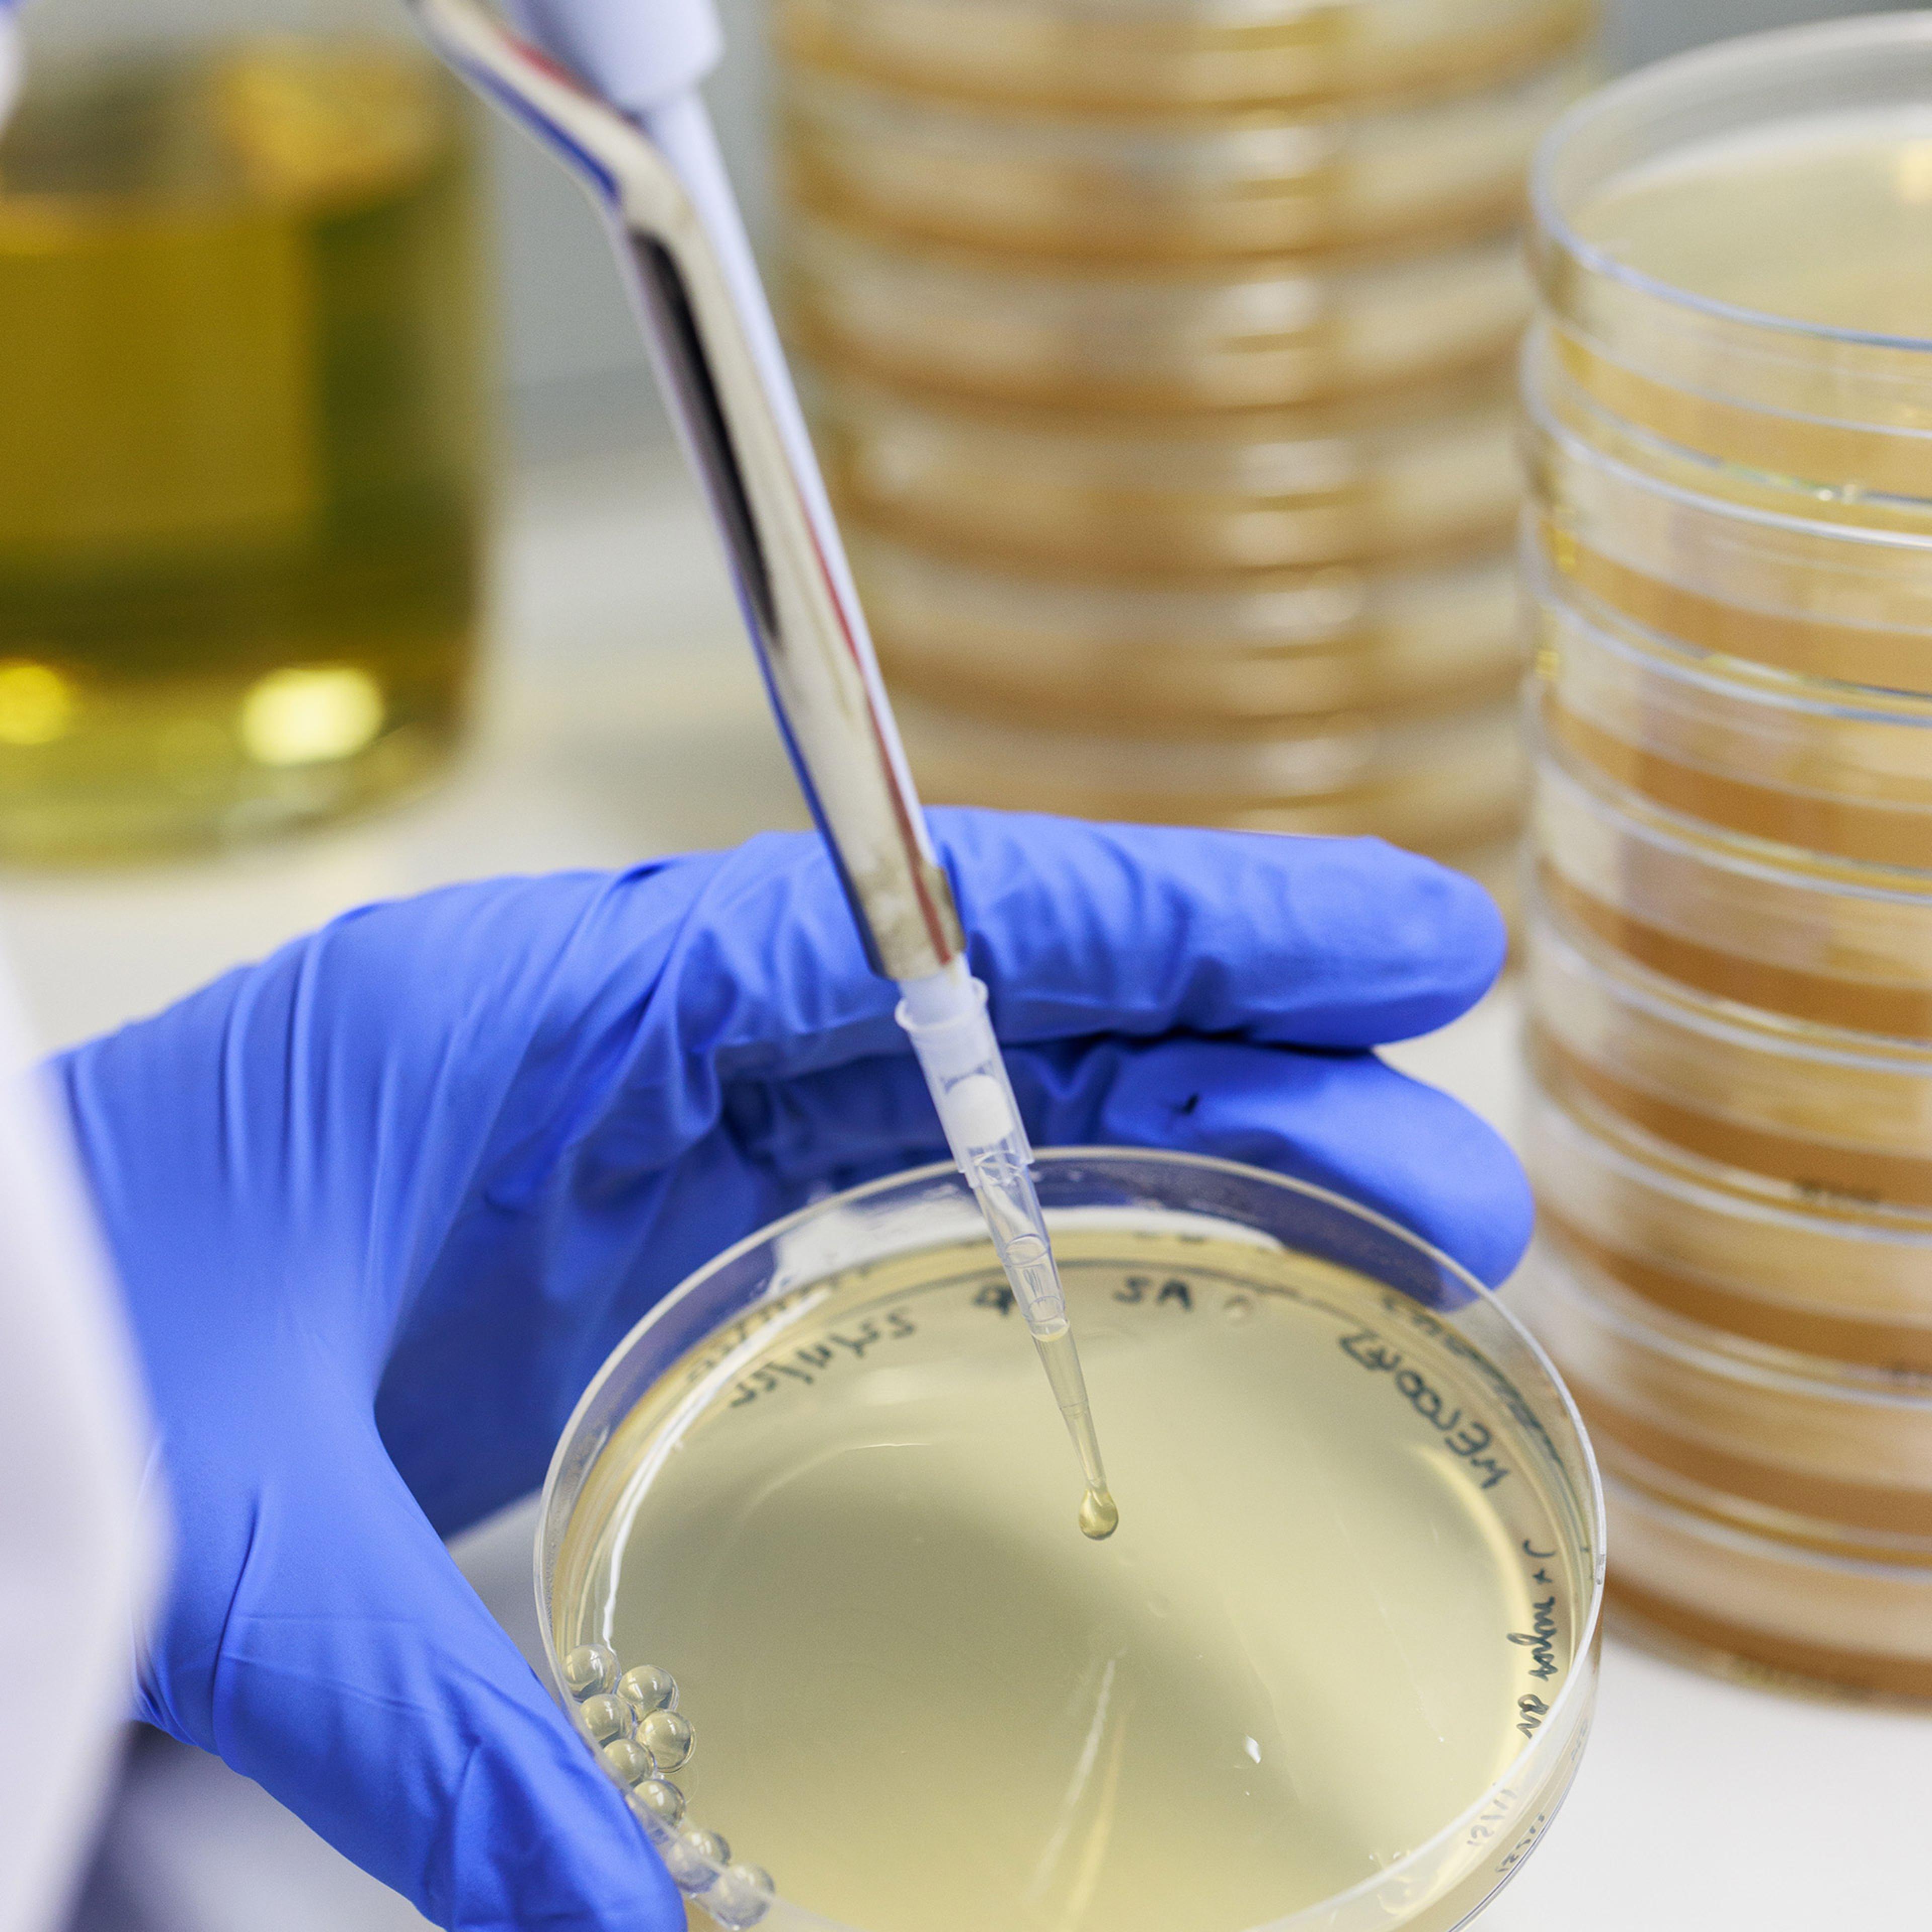
Epoch Biodesign used AI to design enzymes for three major plastic groups, to help process waste.

by Ryan Roslansky and Aneesh Raman

by Ryan Roslansky and Aneesh Raman

by Ravi Kumar S, Andreea Roberts and Simone Crymes

by Eric Schmidt

by Rebecca Hersman and Cassidy Nelson

by Angela Haupt
Advertisement

by Angela Haupt

by Nikita Ostrovsky and Billy Perrigo


by Bruce Schneier and Nathan E. Sanders

by Angela Haupt
Advertisement
by TIME Staff


by Andrew R. Chow and Angela Haupt

by Jessica Smith
